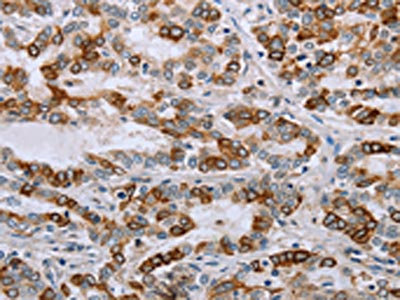

-
中文名稱:NMT1兔多克隆抗體
-
貨號:CSB-PA557232
-
規格:¥1100
-
圖片:
-
The image on the left is immunohistochemistry of paraffin-embedded Human liver cancer tissue using CSB-PA557232(NMT1 Antibody) at dilution 1/45, on the right is treated with synthetic peptide. (Original magnification: ×200)
-
The image on the left is immunohistochemistry of paraffin-embedded Human cervical cancer tissue using CSB-PA557232(NMT1 Antibody) at dilution 1/45, on the right is treated with synthetic peptide. (Original magnification: ×200)
-
-
其他:
產品詳情
-
Uniprot No.:
-
基因名:
-
別名:Alternative, short form NMT S antibody; EC 2.3.1.97 antibody; Glycylpeptide N tetradecanoyltransferase 1 antibody; Glycylpeptide N-tetradecanoyltransferase 1 antibody; Long form, NMT L antibody; Myristoyl CoA:protein N myristoyltransferase 1 antibody; Myristoyl-CoA:protein N-myristoyltransferase 1 antibody; N myristoyltransferase 1 antibody; NMT 1 antibody; NMT antibody; nmt1 antibody; NMT1_HUMAN antibody; Peptide N myristoyltransferase 1 antibody; Peptide N-myristoyltransferase 1 antibody; Type I N myristoyltransferase antibody; Type I N-myristoyltransferase antibody
-
宿主:Rabbit
-
反應種屬:Human,Mouse,Rat
-
免疫原:Synthetic peptide of Human NMT1
-
免疫原種屬:Homo sapiens (Human)
-
標記方式:Non-conjugated
-
抗體亞型:IgG
-
純化方式:Antigen affinity purification
-
濃度:It differs from different batches. Please contact us to confirm it.
-
保存緩沖液:-20°C, pH7.4 PBS, 0.05% NaN3, 40% Glycerol
-
產品提供形式:Liquid
-
應用范圍:ELISA,IHC
-
推薦稀釋比:
Application Recommended Dilution ELISA 1:2000-1:5000 IHC 1:50-1:200 -
Protocols:
-
儲存條件:Upon receipt, store at -20°C or -80°C. Avoid repeated freeze.
-
貨期:Basically, we can dispatch the products out in 1-3 working days after receiving your orders. Delivery time maybe differs from different purchasing way or location, please kindly consult your local distributors for specific delivery time.
-
用途:For Research Use Only. Not for use in diagnostic or therapeutic procedures.
相關產品
靶點詳情
-
功能:Adds a myristoyl group to the N-terminal glycine residue of certain cellular and viral proteins.
-
基因功能參考文獻:
- Genetic and pharmacologic evidence that inhibiting the N-myristoyltransferase NMT1 suppresses cell-cycle progression, proliferation, and malignant growth of prostate cancer cells. PMID: 29038344
- These observations point at a previously unrecognized contribution of calnexin to the retention of NMT1 at the ER membrane. PMID: 26603938
- findings suggest that both NMT1 and hnRNP A2/B1 take part in the regulation of HIV-1 RNA expression through their mutual opposite effects on the viral RNA expression in HIV-1-producing cells PMID: 26074144
- we propose a model of the Nef:NMT complex in which only the myristoyl moiety holds the two proteins together in complex and speculate that perhaps NMT chaperones Nef to the membrane and thereby protects the myristic acid group from the cytosol PMID: 21449607
- In this study, we found decreases in the mRNA levels of human NMT isoforms and the NMT activities in the course of HIV-1 infection in the human T-cell line PMID: 12220649
- role of HSC70 in the regulation of NMT PMID: 15156568
- NMT1 and NMT2 have only partially overlapping functions; NMT1 is critical for tumor cell proliferation PMID: 16123142
- Elevated N-myristoyltransferase activity is associated with oral squamous cell carcinoma PMID: 17549352
- N-myristoyltransferase may have a role in progression of colonic neoplasms PMID: 18021392
- Nef is preferentially myristoylated by NMT2, suggesting that selective inhibition of NMT2 may provide a novel means of blocking HIV virulence. PMID: 18089753
- These results strongly suggest that HIV-1 production is specifically associated with hNMT1, particularly hNMT1(L), but not with hNMT2 in vivo, contributing to the understanding of a step in HIV-1 replication. PMID: 18248763
顯示更多
收起更多
-
亞細胞定位:Cytoplasm. Cytoplasm, cytosol. Membrane; Peripheral membrane protein.
-
蛋白家族:NMT family
-
組織特異性:Heart, gut, kidney, liver and placenta.
-
數據庫鏈接:
Most popular with customers
-
-
YWHAB Recombinant Monoclonal Antibody
Applications: ELISA, WB, IHC, IF, FC
Species Reactivity: Human, Mouse, Rat
-
Phospho-YAP1 (S127) Recombinant Monoclonal Antibody
Applications: ELISA, WB, IHC
Species Reactivity: Human
-
-
-
-
-